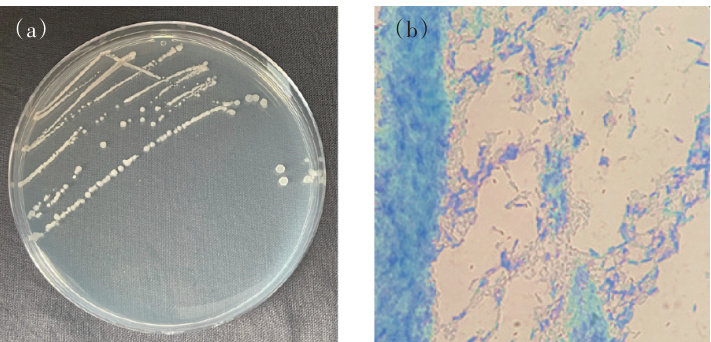

目录
快速导航-

环境健康与农产品安全 | 臭氧浓度升高对大田玉米产量及品质的影响
环境健康与农产品安全 | 臭氧浓度升高对大田玉米产量及品质的影响
-

环境健康与农产品安全 | CO2浓度和温度升高下不同类型水稻高光谱特征及叶绿素含量反演对比分析
环境健康与农产品安全 | CO2浓度和温度升高下不同类型水稻高光谱特征及叶绿素含量反演对比分析
-

环境健康与农产品安全 | 硫化氢信号分子介导S-烯丙基-L-半胱氨酸调控水稻镉胁迫
环境健康与农产品安全 | 硫化氢信号分子介导S-烯丙基-L-半胱氨酸调控水稻镉胁迫
-

环境健康与农产品安全 | pH对水稻幼苗镉亚细胞分布和阳离子通道选择透性的影响
环境健康与农产品安全 | pH对水稻幼苗镉亚细胞分布和阳离子通道选择透性的影响
-

环境健康与农产品安全 | 镉/铅低积累水稻品种筛选及其人体健康风险评价
环境健康与农产品安全 | 镉/铅低积累水稻品种筛选及其人体健康风险评价
-

环境健康与农产品安全 | 不同措施对轻中度镉污染土壤小麦安全生产的影响
环境健康与农产品安全 | 不同措施对轻中度镉污染土壤小麦安全生产的影响
-

环境健康与农产品安全 | 鲜食玉米籽粒镉累积关键影响因子及其影响途径基于随机森林模型
环境健康与农产品安全 | 鲜食玉米籽粒镉累积关键影响因子及其影响途径基于随机森林模型
-

环境健康与农产品安全 | 微塑料-Cd胁迫对蔬菜发芽和幼苗的毒性效应
环境健康与农产品安全 | 微塑料-Cd胁迫对蔬菜发芽和幼苗的毒性效应
-

环境健康与农产品安全 | 叶面喷施L-半胱氨酸对小白菜镉积累及抗氧化系统的影响
环境健康与农产品安全 | 叶面喷施L-半胱氨酸对小白菜镉积累及抗氧化系统的影响
-

环境健康与农产品安全 | 吡噻菌胺对映体在水培黄瓜体系中的选择性吸收与传导行为
环境健康与农产品安全 | 吡噻菌胺对映体在水培黄瓜体系中的选择性吸收与传导行为
-

环境健康与农产品安全 | 山东省主栽设施果类蔬菜养分投入与环境代价
环境健康与农产品安全 | 山东省主栽设施果类蔬菜养分投入与环境代价
-

环境健康与农产品安全 | 不同新型肥料对西南地区露地甘蓝可持续生长综合评价
环境健康与农产品安全 | 不同新型肥料对西南地区露地甘蓝可持续生长综合评价
-

土壤环境 | 高砷地下水灌溉对As在盐渍化农田土壤中迁移的影响
土壤环境 | 高砷地下水灌溉对As在盐渍化农田土壤中迁移的影响
-

土壤环境 | 镉修复微生物菌剂的构建及其作用效果
土壤环境 | 镉修复微生物菌剂的构建及其作用效果
-
土壤环境 | 锰离子胁迫下解淀粉芽孢杆菌A-3代谢响应
土壤环境 | 锰离子胁迫下解淀粉芽孢杆菌A-3代谢响应
-

土壤环境 | 土壤容重和有机质对Cr(Ⅵ)还原转化的影响
土壤环境 | 土壤容重和有机质对Cr(Ⅵ)还原转化的影响
-

土壤环境 | 北京市昌平区农田土壤重金属健康风险评估及来源解析
土壤环境 | 北京市昌平区农田土壤重金属健康风险评估及来源解析
-

土壤环境 | 基于Py-GCMS定量分析不同覆膜年限土壤中微塑料含量以及微生物群落变化
土壤环境 | 基于Py-GCMS定量分析不同覆膜年限土壤中微塑料含量以及微生物群落变化
-

土壤环境 | 中国农用地微塑料分布及其对土壤环境质量影响的Meta分析
土壤环境 | 中国农用地微塑料分布及其对土壤环境质量影响的Meta分析
-

土壤环境 | 还原性绿脱石氧化驱动施化肥和秸秆还田水稻土溶解性有机质转化机制
土壤环境 | 还原性绿脱石氧化驱动施化肥和秸秆还田水稻土溶解性有机质转化机制
-

土壤环境 | 生物炭配施木醋液对盐碱土壤养分及冬小麦耐盐能力的影响
土壤环境 | 生物炭配施木醋液对盐碱土壤养分及冬小麦耐盐能力的影响
-

面源污染 | 宁夏引黄灌区典型田块-沟渠水中氮素浓度的响应特征
面源污染 | 宁夏引黄灌区典型田块-沟渠水中氮素浓度的响应特征
-

面源污染 | 洱海流域有机肥替代化肥对稻鸭共育下水稻产量和田面水氮磷浓度的影响
面源污染 | 洱海流域有机肥替代化肥对稻鸭共育下水稻产量和田面水氮磷浓度的影响
-

水体环境 | 两种合成施氏矿物对Sb(Ⅲ)的吸附特性
水体环境 | 两种合成施氏矿物对Sb(Ⅲ)的吸附特性
-

水体环境 | 球形木质纤维素基阴离子交换剂吸附去除水中Cr(Ⅵ)的性能
水体环境 | 球形木质纤维素基阴离子交换剂吸附去除水中Cr(Ⅵ)的性能
-

水体环境 | 新型磁性生物炭制备及其对水中聚苯乙烯微塑料吸附性能与机制
水体环境 | 新型磁性生物炭制备及其对水中聚苯乙烯微塑料吸附性能与机制
-

废弃物处理及资源化利用 | 猪场沼液组分特征对土壤镉活性的影响
废弃物处理及资源化利用 | 猪场沼液组分特征对土壤镉活性的影响
-

农业与全球变化 | 间作对坡耕地红壤呼吸速率的影响
农业与全球变化 | 间作对坡耕地红壤呼吸速率的影响


 小白菜。此外,PE微塑料抑制了生菜幼苗对Cd的吸收,且抑制作用大于PVC微塑料。研究表明,微塑料与Cd单一及复合污染的毒性作用与微塑料类型和蔬菜种类有关。
小白菜。此外,PE微塑料抑制了生菜幼苗对Cd的吸收,且抑制作用大于PVC微塑料。研究表明,微塑料与Cd单一及复合污染的毒性作用与微塑料类型和蔬菜种类有关。 中游
中游  的影响最大,在酸性条件下吸附效果最佳;吸附等温线符合Langmuir 模型,在常温、中性条件下吸附量约为 40mg?g-1 ;吸附过程符合准二级吸附动力学模型,LCB-AE对Cr(Ⅵ)的吸附为吸热反应,即温度升高促进吸附;通过XPS 对材料进行表征,发现去除机理主要为离子交换,同时存在部分cr(M) 还原转化;共存阴离子( PO43- 、NO-3和 SO42- )竞争吸附、吸附-再生及柱实验表明LCB-AE有较好的选择吸附性能,并能在多次循环中保持稳定,且能够快速吸附水体中的
的影响最大,在酸性条件下吸附效果最佳;吸附等温线符合Langmuir 模型,在常温、中性条件下吸附量约为 40mg?g-1 ;吸附过程符合准二级吸附动力学模型,LCB-AE对Cr(Ⅵ)的吸附为吸热反应,即温度升高促进吸附;通过XPS 对材料进行表征,发现去除机理主要为离子交换,同时存在部分cr(M) 还原转化;共存阴离子( PO43- 、NO-3和 SO42- )竞争吸附、吸附-再生及柱实验表明LCB-AE有较好的选择吸附性能,并能在多次循环中保持稳定,且能够快速吸附水体中的  ,有磁化特性生成(饱和磁化强度
,有磁化特性生成(饱和磁化强度  );试验证实MCB 和MCB-Ni 对PS-MPs 均有吸附能力,其中MCB-Ni 的吸附性能更好,对MPs的最大吸附量为 8 974.40mg?g-1 ,是MCB最大吸附量的3.43倍;酸性条件更有利于MCB和MCB-Ni对MPs的吸附;水中Na+ 及其他离子 (K+?Ca2+?Mg2+?Al3+?Cl-?NO3- 和 SO42- )的存在对MCB和MCB-Ni吸附PS-MPs的抑制作用影响小;吸附-解吸试验结果表明,吸附PS-MPs 后的磁性生物炭可以通过热处理( 500°C )回收,5 次使用后仍具有强的吸附能力( 80% 以上);吸附机理分析结果揭示MCB和MCB-Ni吸附MPs在高温下可以自发进行,主要吸附机制包括孔隙填充、静电吸引、表面络合以及 π-π 相互作用。
);试验证实MCB 和MCB-Ni 对PS-MPs 均有吸附能力,其中MCB-Ni 的吸附性能更好,对MPs的最大吸附量为 8 974.40mg?g-1 ,是MCB最大吸附量的3.43倍;酸性条件更有利于MCB和MCB-Ni对MPs的吸附;水中Na+ 及其他离子 (K+?Ca2+?Mg2+?Al3+?Cl-?NO3- 和 SO42- )的存在对MCB和MCB-Ni吸附PS-MPs的抑制作用影响小;吸附-解吸试验结果表明,吸附PS-MPs 后的磁性生物炭可以通过热处理( 500°C )回收,5 次使用后仍具有强的吸附能力( 80% 以上);吸附机理分析结果揭示MCB和MCB-Ni吸附MPs在高温下可以自发进行,主要吸附机制包括孔隙填充、静电吸引、表面络合以及 π-π 相互作用。 沼液(T6)、 .<1kDa 沼液(T7)8个处理,静置培养 30d 。结果表明,处理组土壤有效态镉含量相较于CK 显著降低,其中T6、T7处理第7天有效态镉含量降低率分别为39.41% 和 31.01% ,第30 天分别为 34.91% 和 53.33% ,降幅显著高于其他处理。研究表明,沼液分子量
沼液(T6)、 .<1kDa 沼液(T7)8个处理,静置培养 30d 。结果表明,处理组土壤有效态镉含量相较于CK 显著降低,其中T6、T7处理第7天有效态镉含量降低率分别为39.41% 和 31.01% ,第30 天分别为 34.91% 和 53.33% ,降幅显著高于其他处理。研究表明,沼液分子量  时对土壤镉的钝化效果较好且更具备稳定性,其作用机理主要是通过改变土壤理化性质、提高土壤有机质荧光组分、芳香性物质和大分子量有机质含量,促进弱酸提取态镉、可还原态镉向可氧化态、残渣态镉的转化,从而降低镉的生物有效性。
时对土壤镉的钝化效果较好且更具备稳定性,其作用机理主要是通过改变土壤理化性质、提高土壤有机质荧光组分、芳香性物质和大分子量有机质含量,促进弱酸提取态镉、可还原态镉向可氧化态、残渣态镉的转化,从而降低镉的生物有效性。 和2.12~5.11μmol?m-2?s-1 ;且间作处理下的土壤呼吸速率整体较其他处理低,IMS 处理下的土壤碳排放总量较MS、MM 处理显著降低了 7.55%.14.65% 。土壤呼吸速率与土壤温度和含水量均呈显著正相关,分别解释了 87.4%~97.0% 和 78.7%~89.5% 的土壤呼吸速率变化,且相较于单一因素模型,双因素模型(土壤温度与土壤含水量)能够更好地解释土壤呼吸速率的变化。间作通过显著提高土壤微生物量碳和土壤微生物量氮的含量,而进一步影响土壤呼吸速率,在玉米生育期内不同种植模式下土壤微生物量碳、氮含量与土壤呼吸存在显著的线性正相关。研究表明,合理的间作模式能降低土壤呼吸速率,减少土壤碳排放。
和2.12~5.11μmol?m-2?s-1 ;且间作处理下的土壤呼吸速率整体较其他处理低,IMS 处理下的土壤碳排放总量较MS、MM 处理显著降低了 7.55%.14.65% 。土壤呼吸速率与土壤温度和含水量均呈显著正相关,分别解释了 87.4%~97.0% 和 78.7%~89.5% 的土壤呼吸速率变化,且相较于单一因素模型,双因素模型(土壤温度与土壤含水量)能够更好地解释土壤呼吸速率的变化。间作通过显著提高土壤微生物量碳和土壤微生物量氮的含量,而进一步影响土壤呼吸速率,在玉米生育期内不同种植模式下土壤微生物量碳、氮含量与土壤呼吸存在显著的线性正相关。研究表明,合理的间作模式能降低土壤呼吸速率,减少土壤碳排放。


















 登录
登录